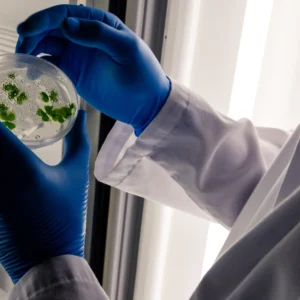
Diplomado en Muestreo y Análisis de Microplásticos Ambientales 2

Ingeniería y Tecnología
-
Diplomado en Muestreo y Análisis de Microplásticos Ambientales
-
Diplomado en Políticas, Gobernanza y Comunicación sobre Microplásticos
-
Diplomado en Tecnologías de Mitigación y Tratamiento de Microplásticos
-
Diplomado en Toxicología y Salud Ambiental por Microplásticos
-
Maestría en Ciencia y Monitoreo Ambiental de Microplásticos
-
Maestría en Economía Circular, Ecodiseño y Sustitución de Plásticos
-
Maestría en Gobernanza, Normativa y Gestión del Riesgo por Microplásticos
-
Maestría en Ingeniería de Tratamiento y Remediación de Microplásticos
-
Maestría en Salud Humana y Toxicología de Micro/Nanoplásticos